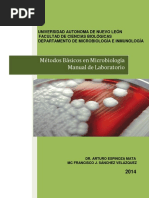
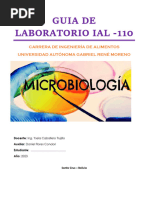

0% encontró este documento útil (0 votos)
152 vistas6 páginasProceso de Desinfección en Laboratorio
Este documento establece las pautas para la limpieza y desinfección del laboratorio de microbiología. Describe los procedimientos para limpiar pisos, superficies, equipos como baños serológicos, microscopios e incubadoras. También detalla los pasos para lavar, desinfectar e esterilizar materiales como pipetas, tubos de ensayo y utensilios antes de su uso en el laboratorio para analizar muestras de alimentos. El objetivo es eliminar microorganismos y prevenir la contaminación.
Cargado por
Angie Tatiana Rodriguez IbañezDerechos de autor
© © All Rights Reserved
Nos tomamos en serio los derechos de los contenidos. Si sospechas que se trata de tu contenido, reclámalo aquí.
Formatos disponibles
Descarga como PDF, TXT o lee en línea desde Scribd
0% encontró este documento útil (0 votos)
152 vistas6 páginasProceso de Desinfección en Laboratorio
Este documento establece las pautas para la limpieza y desinfección del laboratorio de microbiología. Describe los procedimientos para limpiar pisos, superficies, equipos como baños serológicos, microscopios e incubadoras. También detalla los pasos para lavar, desinfectar e esterilizar materiales como pipetas, tubos de ensayo y utensilios antes de su uso en el laboratorio para analizar muestras de alimentos. El objetivo es eliminar microorganismos y prevenir la contaminación.
Cargado por
Angie Tatiana Rodriguez IbañezDerechos de autor
© © All Rights Reserved
Nos tomamos en serio los derechos de los contenidos. Si sospechas que se trata de tu contenido, reclámalo aquí.
Formatos disponibles
Descarga como PDF, TXT o lee en línea desde Scribd